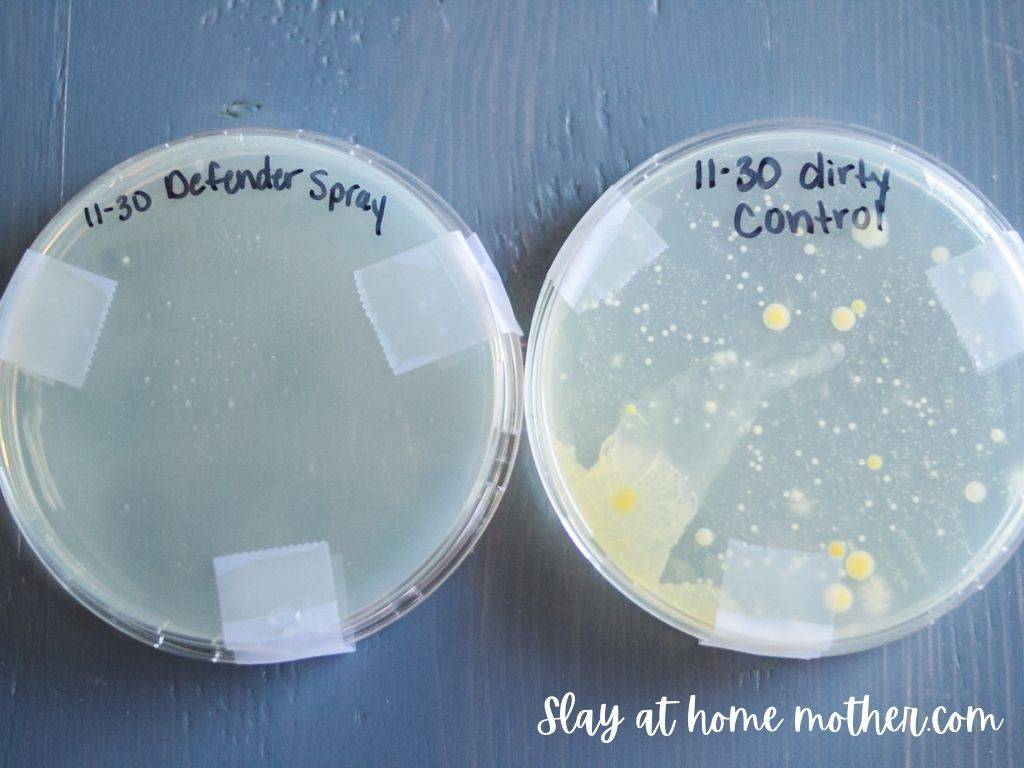
Image

Creating a clean and healthy home doesn’t have to involve harsh chemicals.
Discover the power of DIY disinfectant sprays made with simple, natural ingredients.
These recipes offer effective cleaning and sanitizing power, often with the added bonus of pleasant, natural scents from essential oils.
Keep your living spaces fresh and germ-free the gentle way..
1. Alcohol & Essential Oil Disinfectant Spray

This easy-to-make disinfectant spray harnesses the germ-killing power of high-proof alcohol combined with antimicrobial essential oils.
It’s a quick and effective way to keep surfaces in your home clean without the harsh fumes of store-bought cleaners.
The essential oils add a refreshing scent while boosting the disinfecting action, making it a must-try for a naturally clean home..
Key Ingredients:
Benefits:
- Kills germs
- Natural scent
- Quick to make
Pro Tip: Always clean surfaces with soap and water first to remove physical dirt before disinfecting. This helps the spray work more effectively.
Get the Recipe: Alcohol & Essential Oil Disinfectant Spray
2. Natural Disinfectant Spray with Vodka & Vinegar

Combat germs and viruses naturally with this versatile disinfectant spray.
It offers multiple methods, including options with vodka, white vinegar, or hydrogen peroxide, plus essential oils for added power and a pleasant aroma.
This recipe provides a fantastic alternative to conventional cleaners, leaving your home fresh and sanitized..
Key Ingredients:
Benefits:
- Antibacterial
- Antiviral (with specific formulations)
- Deodorizes
- Kills mold
Pro Tip: For homes with pets, research which essential oils are safe to use, as some can be harmful to furry friends.
Get the Recipe: Natural Disinfectant Spray with Vodka & Vinegar
3. Simple 3-Ingredient Disinfectant Spray

Keep your home healthy and chemical-free with this incredibly simple DIY disinfectant spray.
Requiring just three core ingredients, it’s an easy and budget-friendly way to clean and protect your living spaces.
This recipe is perfect for everyday use, offering peace of mind with its natural formulation..
Key Ingredients:
Benefits:
- Non-toxic
- Inexpensive
- Antimicrobial
Pro Tip: Use cleaning vinegar for an even more potent disinfectant, as it has a higher acidity than standard distilled white vinegar.
Get the Recipe: Simple 3-Ingredient Disinfectant Spray
4. DIY Disinfectant Spray or Wipes with Rubbing Alcohol

Get ready to tackle any mess with this adaptable DIY disinfectant recipe.
You can create either a powerful spray or convenient wipes, perfect for on-the-go sanitizing.
Using rubbing alcohol as a base, it’s a practical solution for keeping your home clean and germ-free, especially when commercial products are hard to find..
Key Ingredients:
Benefits:
- Versatile (spray or wipes)
- Effective sanitizing
- Reusable options
Pro Tip: These homemade wipes can be tossed in the laundry after use, making them an eco-friendly alternative to disposable options.
Get the Recipe: DIY Disinfectant Spray or Wipes with Rubbing Alcohol
5. Alcohol-Based Disinfectant Spray with Essential Oils

This simple disinfectant spray uses readily available rubbing alcohol to create a powerful cleaning solution.
It’s a great way to keep germs at bay without resorting to harsh chemicals.
Adding essential oils transforms the scent, making your cleaning routine more pleasant and the spray even more effective..
Key Ingredients:
Benefits:
- Easy to make
- Kills germs and bacteria
- Pleasant scent (with EOs)
Pro Tip: If you can only find 70% isopropyl alcohol, you can use it directly without diluting the water for effective germ-killing power.
Get the Recipe: Alcohol-Based Disinfectant Spray with Essential Oils
6. Thyme & Rubbing Alcohol Disinfectant Spray

Banish bugs naturally with this effective DIY disinfectant spray.
It uses potent thyme essential oil and 70% rubbing alcohol to create a powerful solution for soft surfaces.
This recipe offers a safe and eco-friendly way to keep your home clean and healthy, banishing germs without harming your well-being or the environment..
Key Ingredients:
Benefits:
- Antibacterial
- Antimicrobial
- Non-toxic
Pro Tip: Always use a glass spray bottle for disinfectant sprays containing essential oils, as they can degrade plastic over time.
Get the Recipe: Thyme & Rubbing Alcohol Disinfectant Spray
7. 2-Ingredient Bleach Disinfectant Spray

Achieve a germ-free kitchen with this super simple DIY disinfectant spray.
Requiring just two common household items, it’s an effective way to sanitize surfaces like countertops and cutting boards.
This recipe is a budget-friendly solution for keeping your home clean and safe, especially after meal prep..
Key Ingredients:
Benefits:
- Kills 99.99% of germs
- Easy to make
- Effective on sticky messes
Pro Tip: Always use bleach in a well-ventilated area and wear gloves to protect your skin. Clean surfaces first if they have significant dirt or food residue.
Get the Recipe: 2-Ingredient Bleach Disinfectant Spray
8. Essential Oil Disinfectant Cleaning Spray

Clean and freshen your home simultaneously with this natural, non-toxic disinfectant spray.
It powerfully disinfects, sanitizes, deodorizes, and combats mold and mildew, all while leaving a wonderfully clean scent.
This essential oil blend is a fantastic alternative to harsh chemicals, making your home smell amazing and feel deeply clean..
Key Ingredients:
- High-proof alcohol (70%+)
- Hydrogen peroxide
- Tea tree essential oil
- Lemon essential oil
- Lavender essential oil
- Eucalyptus essential oil
Benefits:
- Natural
- Non-toxic
- Powerful cleaner
- Fights mold & mildew
Pro Tip: Shake the spray bottle well before each use to ensure the essential oils are evenly distributed for maximum effectiveness.
Get the Recipe: Essential Oil Disinfectant Cleaning Spray
9. All-Purpose Disinfectant Spray with Rubbing Alcohol and Essential Oils

This easy-to-make disinfectant spray uses rubbing alcohol as its powerful cleaning base, enhanced with the antibacterial and antiviral properties of tea tree, lemon, and lavender essential oils.
It’s a fantastic all-purpose cleaner that leaves a refreshing scent and effectively sanitizes common household surfaces like doorknobs, countertops, and phones.
Say goodbye to strong chemical smells and hello to a naturally clean home..
Key Ingredients:
Benefits:
- Antibacterial
- Antiviral
- Antifungal
- Freshens Air
Pro Tip: If you have cats, be mindful that tea tree oil can be toxic to them. Consider substituting it with another essential oil like eucalyptus or rosemary.
Get the Recipe: All-Purpose Disinfectant Spray with Rubbing Alcohol and Essential Oils
10. Powerful Disinfectant Spray with Alcohol and Essential Oils

Harness the natural power of essential oils for a truly effective disinfectant spray.
This recipe uses a high-proof alcohol base, combined with beneficial oils like tea tree, lemon, and lavender, known for their antimicrobial and antiviral properties.
It’s a simple yet potent solution to keep your home germ-free, leaving behind a pleasant, natural aroma..
Key Ingredients:
- High Proof Alcohol (70% or higher)
- Lavender Essential Oil
- Tea Tree Essential Oil
- Lemon Essential Oil
Benefits:
- Antimicrobial
- Antibacterial
- Antifungal
- Degreaser
Pro Tip: When blending essential oils, consider using glass bottles for storage, as some strong oils can react with metal over time.
Get the Recipe: Powerful Disinfectant Spray with Alcohol and Essential Oils
11. Simple Vinegar and Essential Oil Disinfectant Spray

This straightforward disinfectant spray relies on the cleaning power of white vinegar and the antibacterial benefits of tea tree and lavender essential oils.
It’s a non-toxic and eco-friendly option for everyday cleaning, safe enough to use around kids and pets.
Just shake well and spray to keep your surfaces fresh and clean..
Key Ingredients:
Benefits:
- Multipurpose Disinfectant
- Antiviral
- Antifungal
- Non-Toxic
Pro Tip: Always use a glass spray bottle, as essential oils can degrade plastic over time.
Get the Recipe: Simple Vinegar and Essential Oil Disinfectant Spray
12. Alcohol-Based Disinfectant Spray with Hydrogen Peroxide and Essential Oils

Create a powerful germ-killer with this alcohol-based disinfectant spray.
It combines high-proof alcohol with a touch of hydrogen peroxide and a blend of antiviral essential oils for a super effective cleaner.
This affordable DIY spray is perfect for tackling high-touch surfaces and leaving your home smelling naturally fresh..
Key Ingredients:
- High Proof Alcohol (Ethanol or Isopropyl)
- Distilled Water
- Hydrogen Peroxide
- Essential Oils (e.g., Tea Tree, Eucalyptus, Lemon)
Benefits:
- Antiviral
- Antibacterial
- Cost-Effective
- Customizable Scent
Pro Tip: Ensure your alcohol content is at least 60% for effective disinfection. You can use a calculator or hydrometer to verify.
Get the Recipe: Alcohol-Based Disinfectant Spray with Hydrogen Peroxide and Essential Oils
13. Non-Toxic Disinfectant Spray with Rubbing Alcohol and Essential Oils

Keep your home safe and clean with this homemade disinfectant spray featuring rubbing alcohol and a blend of uplifting essential oils like orange, cinnamon, and clove.
It’s a wonderful way to sanitize surfaces naturally, tackling germs while leaving a warm, inviting scent.
This recipe is a great alternative to conventional cleaners, promoting a healthier living space..
Key Ingredients:
- Rubbing Alcohol
- Filtered Water
- Castile Soap
- Orange Essential Oil
- Cinnamon Essential Oil
- Nutmeg Essential Oil
- Clove Essential Oil
- Ginger Essential Oil
Benefits:
- Antibacterial
- Germ Fighter
- Odor Eliminator
- Uplifting Aroma
Pro Tip: Experiment with different essential oil combinations for a scent that perfectly suits your home, like a pumpkin spice blend for the fall.
Get the Recipe: Non-Toxic Disinfectant Spray with Rubbing Alcohol and Essential Oils
14. Natural Kitchen Surface Cleaner with Lemon and Vinegar

Keep your kitchen surfaces fresh and clean with this all-purpose natural cleaner.
It features the degreasing power of white vinegar and the antibacterial properties of real lemon juice, creating a wonderfully fresh scent.
This simple, cost-effective recipe is safe for use around family and leaves your kitchen sparkling..
Key Ingredients:
- White Distilled Vinegar
- Distilled Water
- Fresh Lemon Juice
- Liquid Castile Soap (optional)
- Essential Oil (optional)
Benefits:
- Natural Disinfectant
- Cost-Effective
- Fresh Scent
- Safe for Kids
Pro Tip: Avoid using this cleaner on natural stone surfaces like marble or granite due to the acidity of vinegar and lemon juice.
Get the Recipe: Natural Kitchen Surface Cleaner with Lemon and Vinegar
15. DIY Disinfecting Spray with Colloidal Silver and Tea Tree Oil

This simple DIY spray offers a natural way to keep your home clean, moving away from harsh chemicals often found in conventional disinfectants.
It combines filtered water with colloidal silver, known for its antimicrobial properties, and potent tea tree oil, a natural antifungal and antiviral agent.
You can also add vodka as a preservative and to enhance the aroma of added essential oils like thyme, rosemary, lavender, or lemongrass, creating a purifying spray that leaves your space smelling fresh..
Key Ingredients:
Benefits:
- Natural Disinfection
- Purifies Air
- Reduces Harsh Chemicals
Pro Tip: Using Miron violet glass spray bottles can act as a natural preservative, potentially allowing you to skip the vodka.
Get the Recipe: DIY Disinfecting Spray with Colloidal Silver and Tea Tree Oil
16. Citrus-Infused Vinegar All-Purpose Cleaner

Say goodbye to harsh chemicals with this refreshing homemade all-purpose cleaner! By infusing white vinegar with citrus peels, you create a powerful cleaner that effectively cuts through dirt and grime, leaving surfaces super shiny and smelling wonderfully fresh.
This recipe is a fantastic way to reduce waste by using leftover peels, and it’s gentle enough for those with sensitive skin while still being tough on messes.
It’s a must-try for an eco-friendly and budget-conscious clean..
Key Ingredients:
Benefits:
- Cuts Grease and Grime
- Leaves Surfaces Shiny
- Refreshing Natural Scent
Pro Tip: Experiment with other herbs and spices like sage, rosemary, or lavender during the infusion process for unique scent variations.
Get the Recipe: Citrus-Infused Vinegar All-Purpose Cleaner
17. DIY Anti-Mold Spray with Vinegar and Essential Oils

Keep your bathroom and kitchen free from mold and mildew with this effective DIY anti-mold spray.
Made with simple, all-natural ingredients like vinegar and essential oils, it’s a powerful solution for tackling damp areas.
The vinegar helps kill mold species, while essential oils like tea tree and lemon add extra purifying power.
This spray leaves your space smelling fresh and clean, offering a natural defense against unwanted growth..
Key Ingredients:
Benefits:
- Kills Mold and Mildew
- Freshens Spaces
- Natural Defense Against Growth
Pro Tip: For tougher mold spots, start by making a thin paste of baking soda and water to apply before using the vinegar spray.
Get the Recipe: DIY Anti-Mold Spray with Vinegar and Essential Oils
18. Simple Homemade All-Purpose Cleaning Spray

Whip up an effective all-purpose cleaner with just a few simple ingredients you likely already have at home.
This budget-friendly DIY spray is great for tackling everyday messes on countertops, in the bathroom, and on surfaces around your house.
By using natural ingredients and avoiding harsh chemicals, you can keep your home sparkling clean and safe for family and pets.
It’s a truly easy and economical way to maintain a clean living space..
Key Ingredients:
- Warm water
- Liquid castile soap
- Washing soda or borax
- Essential oils (tea tree, grapefruit seed, lemon)
Benefits:
- Effective Everyday Cleaning
- Safe for Kids and Pets
- Inexpensive to Make
Pro Tip: Opt for glass spray bottles for a more sustainable and visually appealing cleaning solution.
Get the Recipe: Simple Homemade All-Purpose Cleaning Spray
19. DIY All-Purpose Cleaner with Vinegar and Dish Soap

Keep your home sparkling clean without harsh chemicals using this super easy DIY all-purpose cleaner.
It effectively tackles grime on countertops, appliances, and surfaces throughout your home, making it safe for use around kids and pets.
This simple recipe combines just three ingredients to create a powerful cleaner that works on just about any non-porous surface, ensuring a fresh and clean environment without the worry of toxic fumes..
Key Ingredients:
Benefits:
- Non-Toxic Cleaning
- Cuts Through Grime
- Safe for Families
Pro Tip: The foaming action created by mixing baking soda and vinegar is a fun part of the process, especially for kids!
Get the Recipe: DIY All-Purpose Cleaner with Vinegar and Dish Soap
20. Natural Disinfectant Spray with Alcohol and Essential Oils

Tired of toxic Lysol? This natural disinfectant spray offers a powerful alternative using alcohol and a blend of germ-fighting essential oils like tea tree, lemon, and lavender.
It’s designed to tackle germs and viruses, leaving surfaces clean and your home smelling wonderfully fresh without the harsh chemicals found in conventional cleaners.
Keep your home healthy and embrace a more natural approach to disinfecting..
Key Ingredients:
- Alcohol (70%)
- Hydrogen peroxide
- Tea Tree essential oil
- Lemon essential oil
- Lavender essential oil
- Eucalyptus essential oil
Benefits:
- Kills Germs and Viruses
- Fresh Natural Scent
- Reduces Toxin Exposure
Pro Tip: Having a backup essential oil diffuser is a great idea for keeping the air purified when someone is sick.
Get the Recipe: Natural Disinfectant Spray with Alcohol and Essential Oils
21. Natural Bathroom Disinfectant Spray with Alcohol and Baking Soda

Simplify your bathroom cleaning routine with this all-in-one natural disinfectant spray! It effectively cleans, scrubs, and disinfects all hard surfaces, from sinks to toilets, using simple ingredients like alcohol, baking soda, and essential oils.
Not only is it safer for your family and the environment, but it also saves you money and storage space by replacing multiple products.
Get your bathroom germ-free and smelling fresh with this easy DIY solution..
Key Ingredients:
- Warm Water
- Baking Soda
- Alcohol (ethyl or isopropyl)
- Tea Tree Oil (optional)
- Lemon Essential Oil (optional)
Benefits:
- Disinfects Surfaces
- Eliminates Odors
- Safer for Home and Environment
Pro Tip: Shake the bottle well before each use, as the essential oils may naturally separate over time.
Get the Recipe: Natural Bathroom Disinfectant Spray with Alcohol and Baking Soda
22. Homemade Bleach Alternative with Hydrogen Peroxide and Lemon Juice

Tackle tough cleaning jobs without the harshness of chlorine bleach! This homemade bleach alternative uses the power of hydrogen peroxide and lemon juice to whiten and brighten laundry and clean surfaces.
It’s a beautifully effective way to get sparkling results while keeping your home free from toxic side effects.
Simply mix a few common ingredients for a powerful, natural cleaning solution that’s much safer for your family and the environment..
Key Ingredients:
Benefits:
- Whitens and Brightens
- Removes Tough Stains
- Non-Toxic Alternative
Pro Tip: Store this bleach alternative in an amber glass jar to protect the hydrogen peroxide from light and extend its shelf life.
Get the Recipe: Homemade Bleach Alternative with Hydrogen Peroxide and Lemon Juice
23. Hydrogen Peroxide & Essential Oil Disinfectant Spray

This powerful DIY disinfectant spray uses hydrogen peroxide to tackle germs and viruses effectively.
It’s a fantastic way to clean and disinfect surfaces, mimicking the efficacy of store-bought cleaners without the harsh chemicals.
Adding essential oils can provide a pleasant scent and extra cleaning boost, leaving your home smelling fresh and looking spotless..
Key Ingredients:
Benefits:
- Disinfects surfaces
- Kills viruses and bacteria
- Natural alternative to commercial cleaners
Pro Tip: Always use a dark-colored spray bottle for hydrogen peroxide, as it can degrade when exposed to light.
Get the Recipe: Hydrogen Peroxide & Essential Oil Disinfectant Spray
24. All-Purpose Vinegar & Essential Oil Cleaner

Whip up a simple yet effective all-purpose cleaner with just white vinegar, water, and a few drops of essential oils.
This spray is perfect for windows, mirrors, countertops, and even floors, leaving them streak-free and smelling wonderfully fresh.
It’s a cost-effective and eco-friendly way to keep your home clean and odor-free..
Key Ingredients:
Benefits:
- Cleans effectively
- Neutralizes odors
- Streak-free shine
Pro Tip: For a pleasant scent, try lemon, lavender, or tea tree essential oils. For tougher jobs, let the spray sit for a minute before wiping.
Get the Recipe: All-Purpose Vinegar & Essential Oil Cleaner
25. Rubbing Alcohol, Vinegar & Essential Oil Disinfectant

This DIY cleaning spray combines the disinfecting power of rubbing alcohol with the cleaning properties of vinegar, all enhanced by the fresh scent of essential oils.
It’s a robust solution for keeping your home clean and germ-free, making it a must-try for anyone looking for a natural approach to household cleaning..
Key Ingredients:
Benefits:
- Disinfects surfaces
- Effective cleaner
- Pleasant scent
Pro Tip: Experiment with different essential oil blends like lavender-lemon or a citrus mix for a custom scent.
Get the Recipe: Rubbing Alcohol, Vinegar & Essential Oil Disinfectant
26. Defender Essential Oil Disinfectant Spray
Harness the power of essential oils with this natural disinfectant spray.
Using a blend like ‘Defender’ (often a mix of cinnamon, rosemary, lemon, eucalyptus, and clove) alongside witch hazel and water, this spray is designed to tackle germs and leave your home smelling wonderfully natural and clean.
It’s a great option for cleaning high-touch surfaces like doorknobs and handles..
Key Ingredients:
Benefits:
- Natural germ fighter
- Pleasant aroma
- Portable for on-the-go use
Pro Tip: This spray is perfect for on-the-go, easily fitting into a diaper bag or purse to tackle germs wherever you are.
Get the Recipe: Defender Essential Oil Disinfectant Spray
27. DIY Thieves All-Purpose Cleaner

This DIY Thieves All-Purpose Cleaner is a wonderful alternative to commercial cleaners, using a blend of essential oils known for their cleaning power.
It leaves your home smelling like a cozy holiday season while effectively tackling messes.
Made with ingredients like clove, lemon, cinnamon, eucalyptus, and rosemary oils, it’s a natural way to disinfect and clean without harsh toxins.
It’s a cost-effective and safe option for families..
Key Ingredients:
- Clove oil
- Lemon oil
- Cinnamon oil
- Eucalyptus oil
- Rosemary oil
- Witch hazel
- Lemon juice or citric acid
- Distilled water
Benefits:
- Natural disinfection
- Toxin-free cleaning
- Pleasant scent
- Cost-effective
Pro Tip: For surfaces like granite or natural stone, consider leaving out the lemon juice or citric acid to prevent etching. Always do a patch test if you’re unsure about a new surface.
Get the Recipe: DIY Thieves All-Purpose Cleaner
28. Natural Hand Sanitizer Spray with Essential Oils

This easy-to-make hand sanitizer spray offers a natural, non-toxic way to keep your hands clean on the go.
It uses witch hazel or rubbing alcohol as a base, boosted with essential oils like cinnamon, clove, eucalyptus, orange, and rosemary for their antibacterial properties.
It’s a light and convenient option for disinfecting hands when soap and water aren’t available, leaving a pleasant scent without harsh chemicals..
Key Ingredients:
- Rubbing Alcohol or Witch Hazel
- Vegetable Glycerin
- Cinnamon Essential Oil
- Clove Essential Oil
- Eucalyptus Essential Oil
- Orange Essential Oil
- Rosemary Essential Oil
Benefits:
- Natural disinfecting
- Convenient for on-the-go
- Toxin-free
- Aromatherapeutic benefits
Pro Tip: Always use dark-colored glass bottles to store your hand sanitizer, as essential oils can degrade plastic and sunlight can reduce the oils’ effectiveness.
Get the Recipe: Natural Hand Sanitizer Spray with Essential Oils
29. Simple 3-Ingredient All-Purpose Cleaner

This incredibly simple 3-ingredient all-purpose cleaner is a game-changer for eco-friendly cleaning.
Combining water, distilled white vinegar, and essential oils, it’s perfect for tackling germs and grime on most surfaces.
It’s a budget-friendly and healthy alternative to chemical cleaners, leaving behind a fresh scent thanks to the essential oils.
It’s so easy to make, you’ll wonder why you didn’t start sooner!.
Key Ingredients:
Benefits:
- Effective germ killer
- Cost-effective
- Natural ingredients
- Pleasant aroma
Pro Tip: This cleaner is fantastic for most surfaces, but it’s best to avoid using it on marble or granite as vinegar can etch these materials.
Get the Recipe: Simple 3-Ingredient All-Purpose Cleaner
30. DIY Vinegar Bathroom Cleaner

This DIY Vinegar Bathroom Cleaner is a simple yet powerful solution for keeping your bathroom sparkling.
Using just white vinegar and water, it naturally cuts through grease, dissolves mineral deposits, and tackles most bacteria and mold without harsh fumes.
Adding essential oils like tea tree, lavender, or lemon provides a fresh scent and extra cleaning power, making your bathroom feel clean and inviting..
Key Ingredients:
Benefits:
- Natural cleaning power
- Tackles soap scum and hard water stains
- Odor neutralizer
- Cost-effective
Pro Tip: For tougher grime, try warming the vinegar slightly before mixing it with water; warm liquids can penetrate dirt more effectively.
Get the Recipe: DIY Vinegar Bathroom Cleaner






